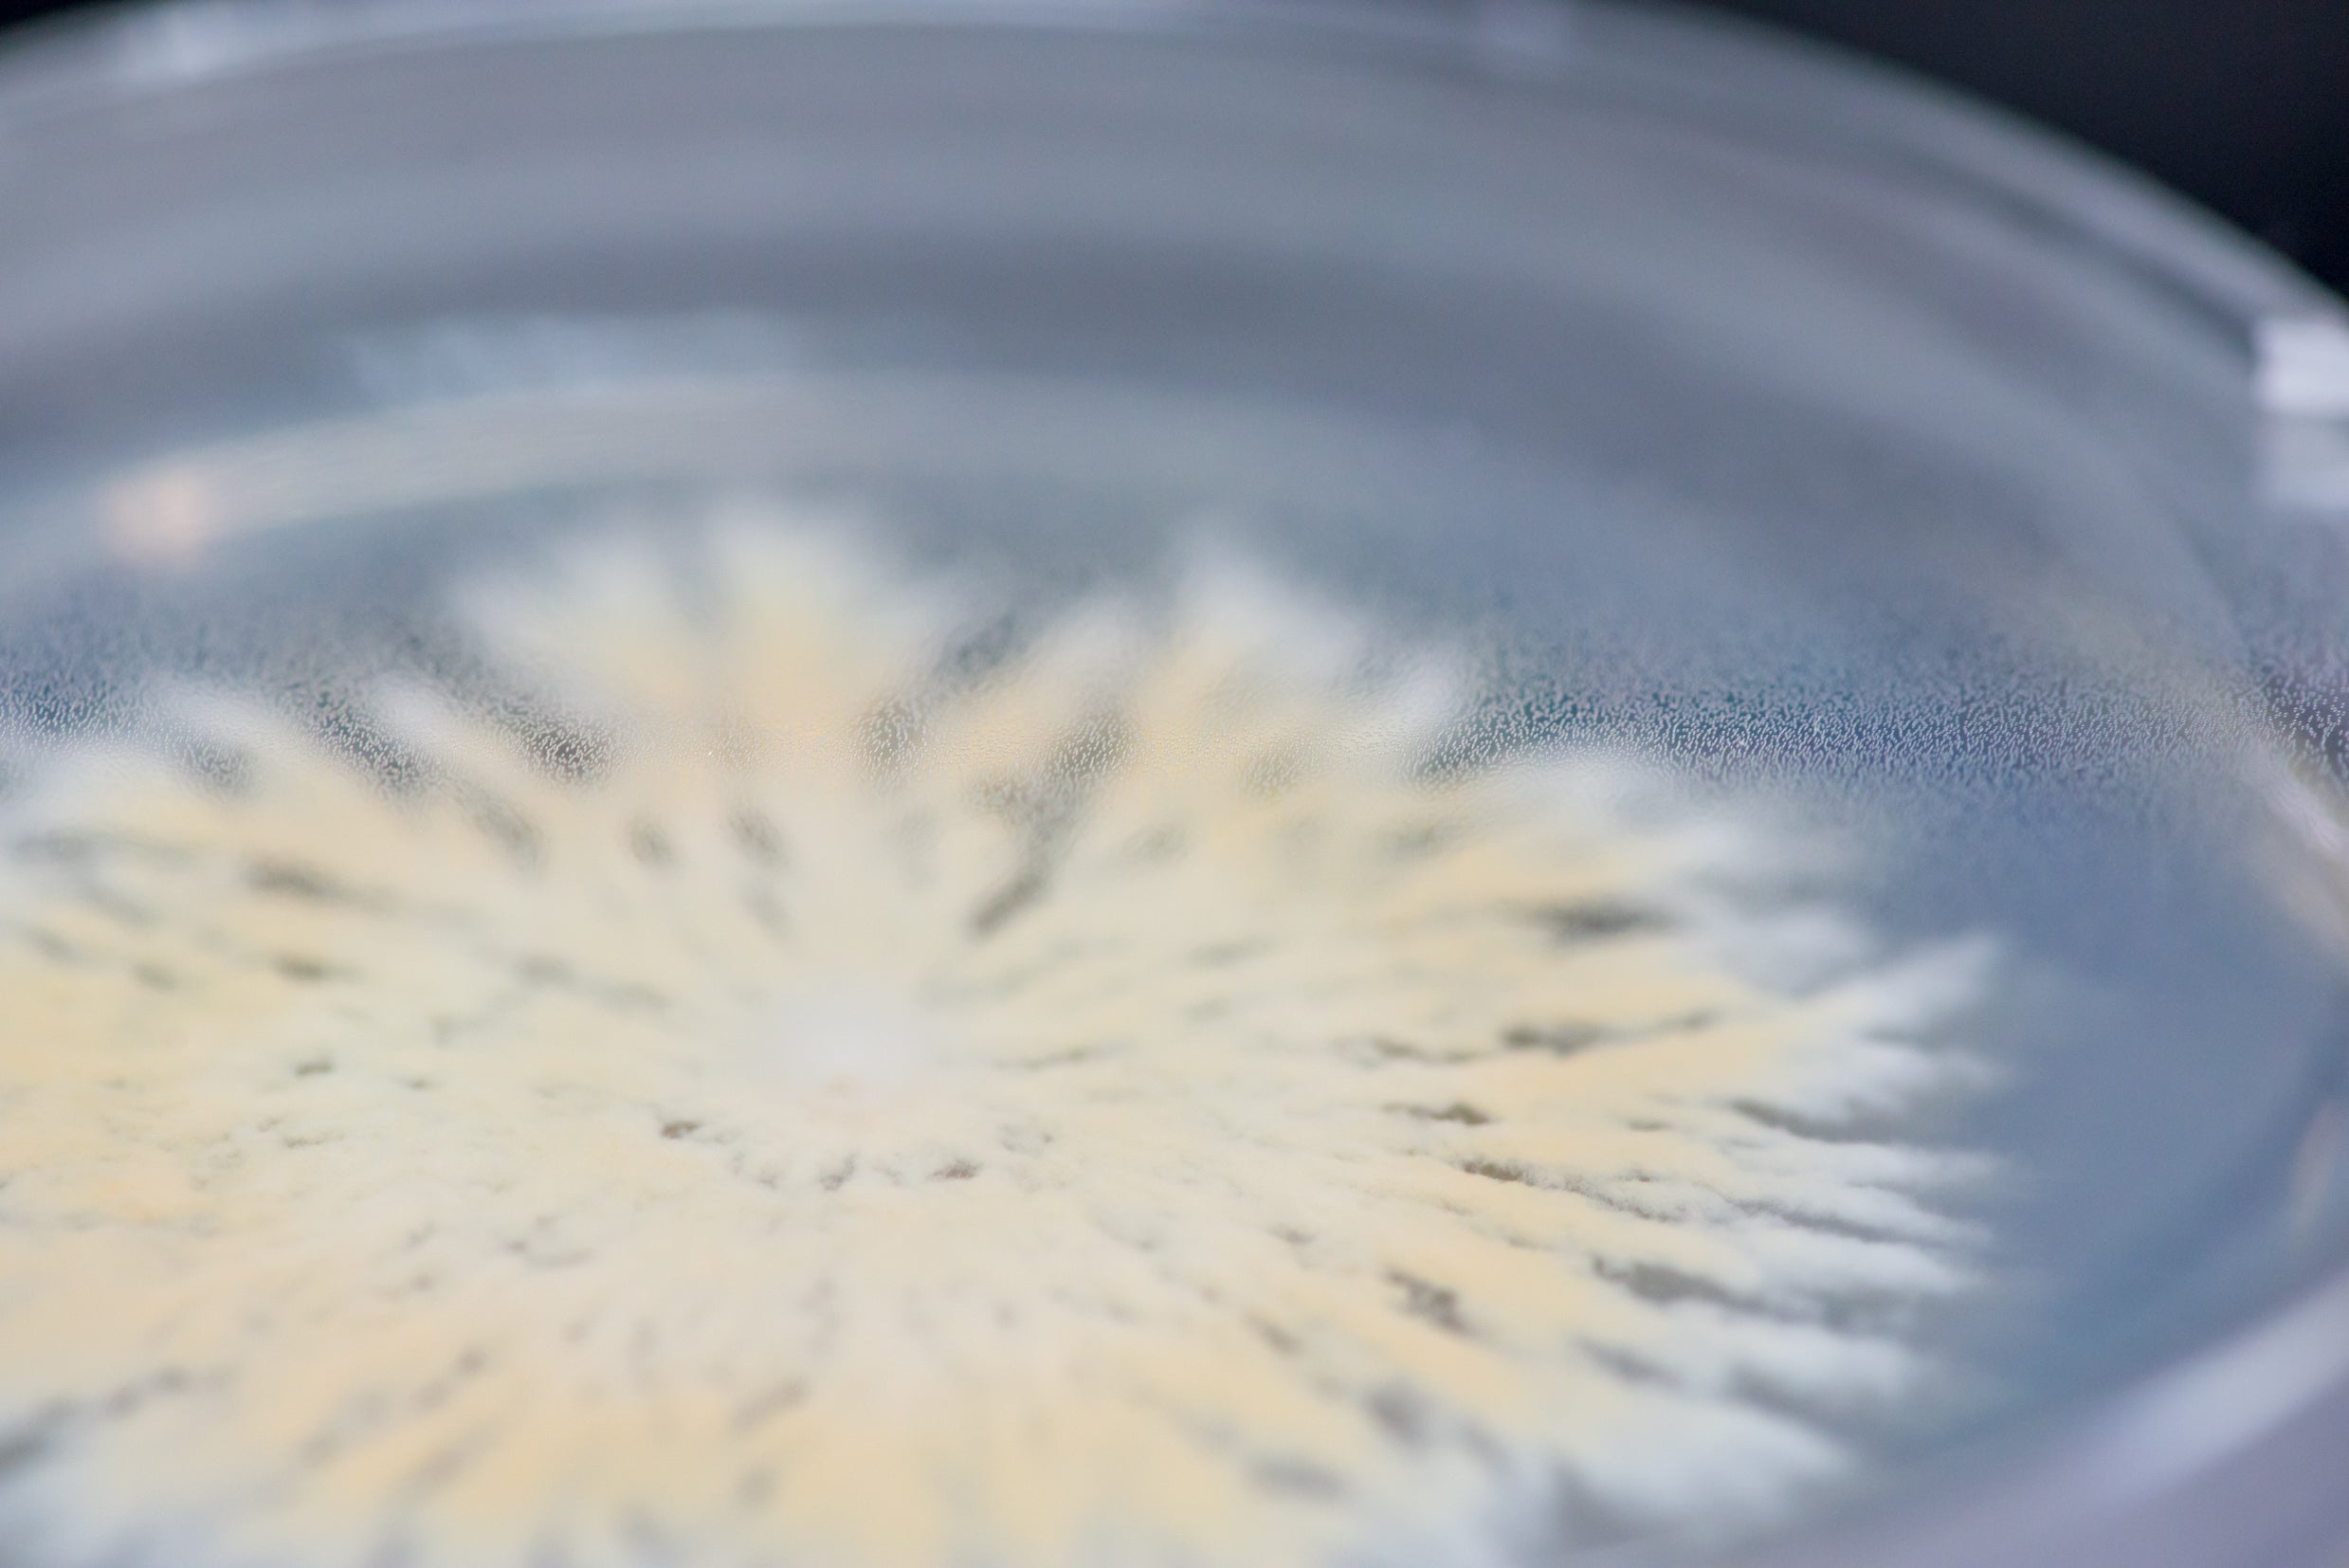

-
Black Pearl King Oyster Mushroom
Regular price From £0.00 GBPRegular priceUnit price / per -
Blue-Grey Oyster Mushroom
Regular price From £7.99 GBPRegular priceUnit price / per -
Enoki Mushroom
Regular price From £0.00 GBPRegular priceUnit price / per -
Florida Oyster Mushroom
Regular price From £7.99 GBPRegular priceUnit price / per
Unveiling nature's hidden treasures with premium mycological products.